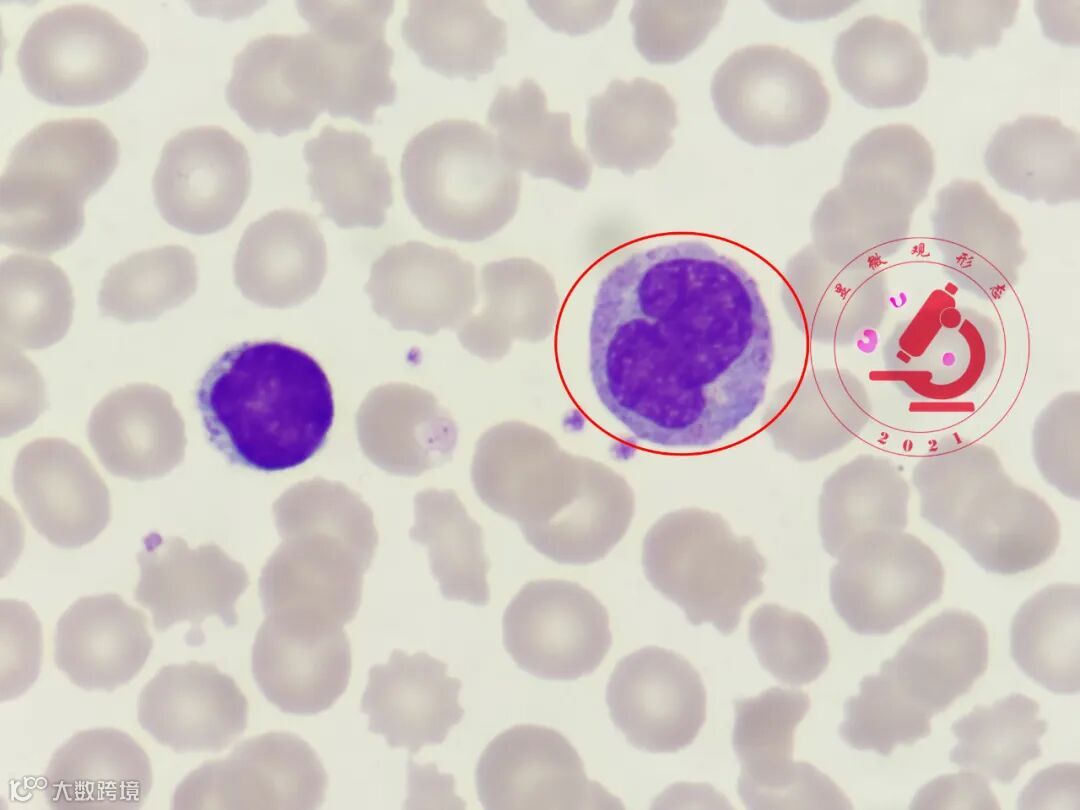
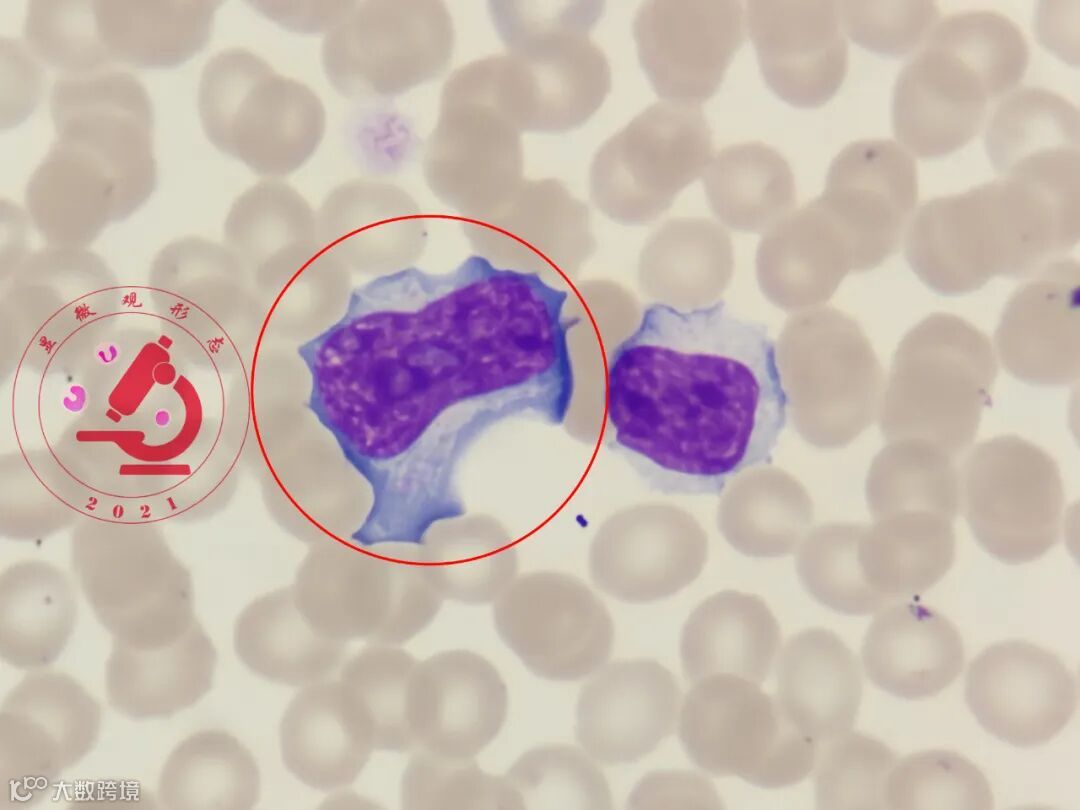
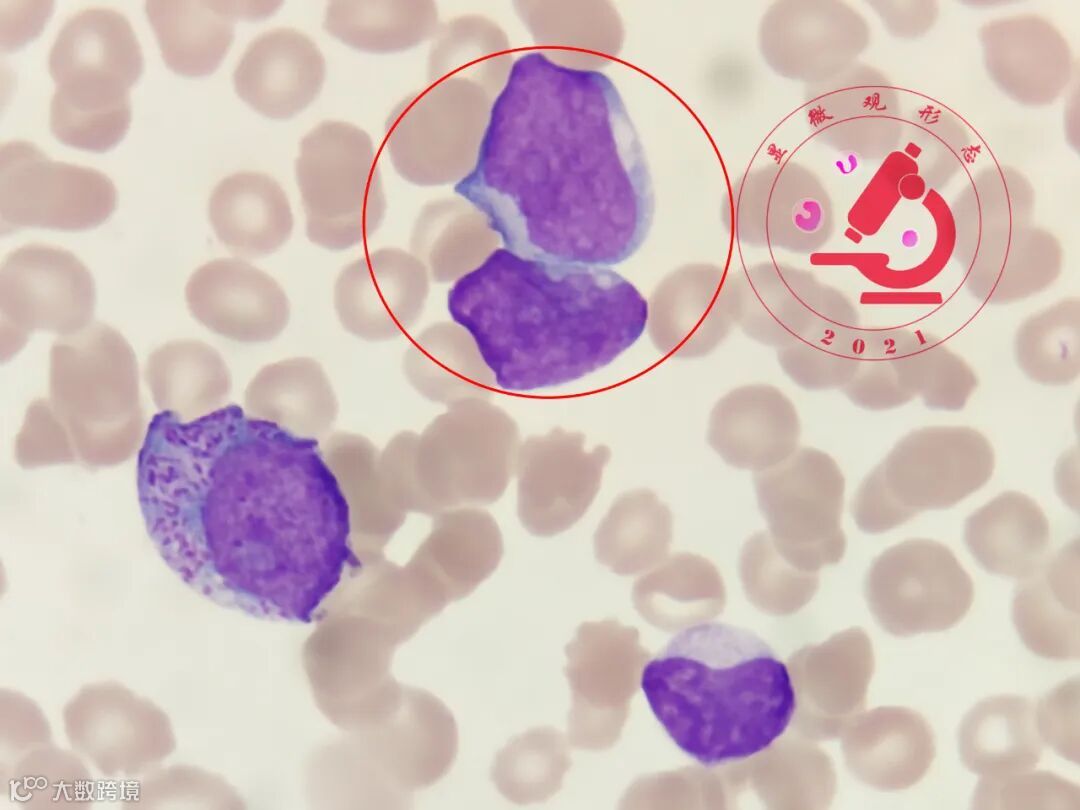
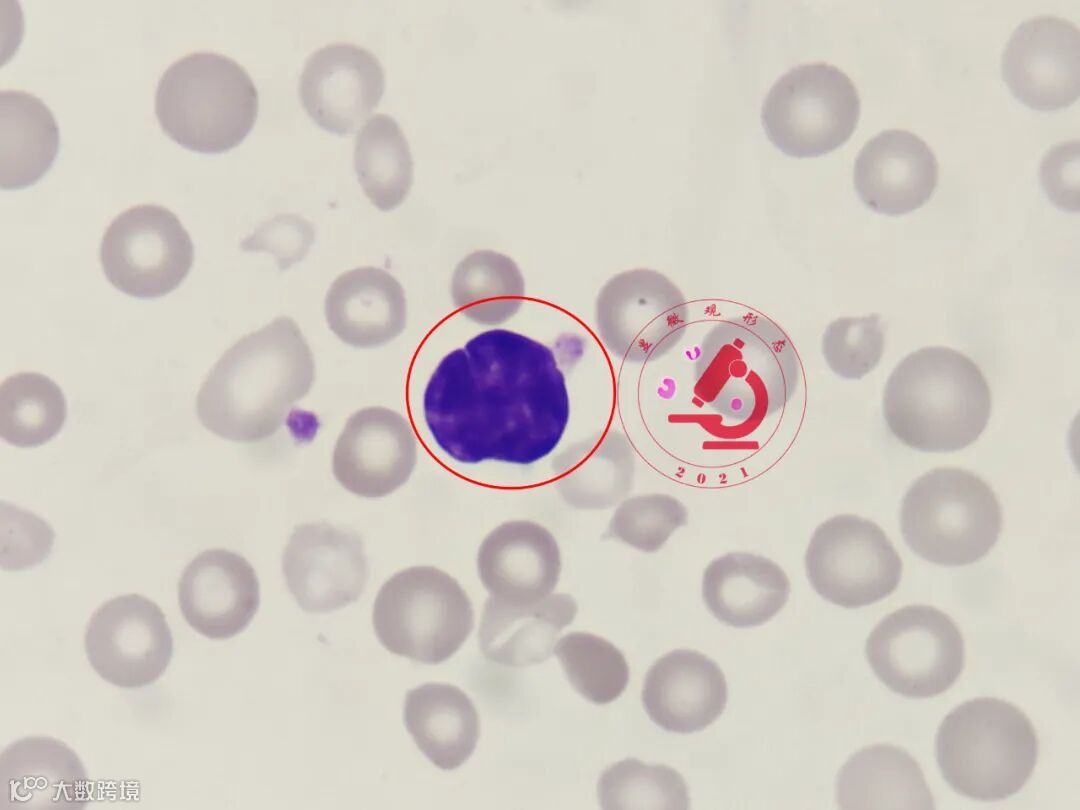
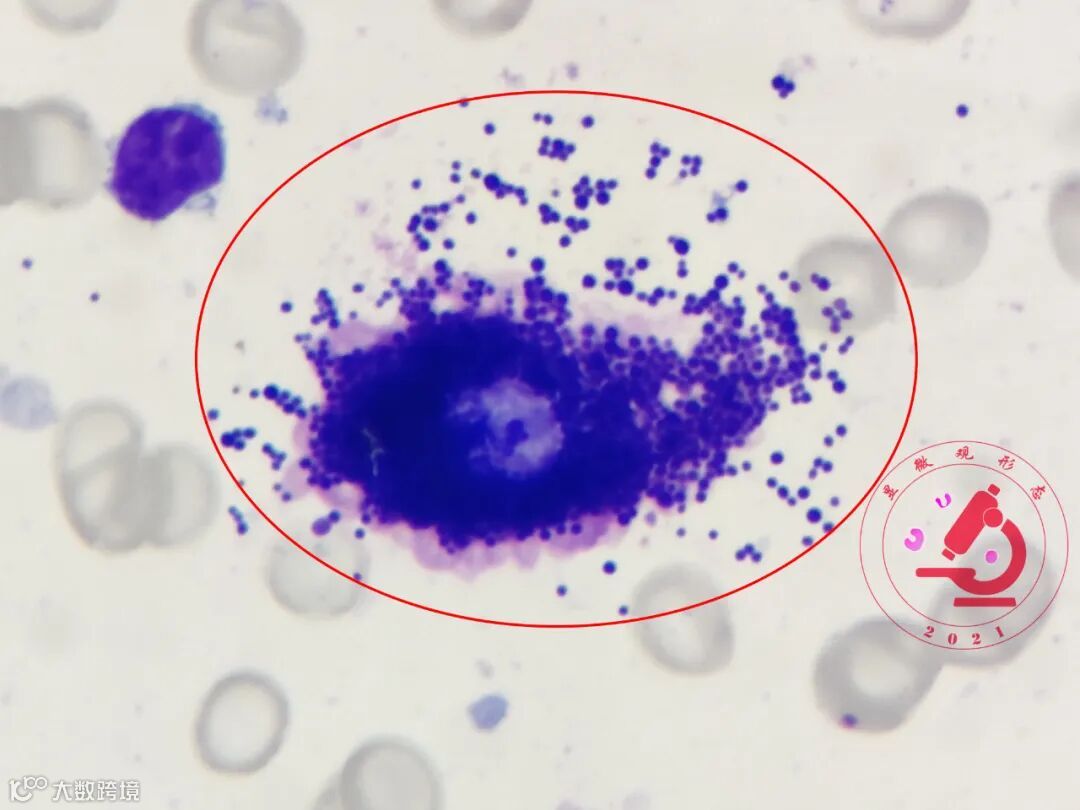
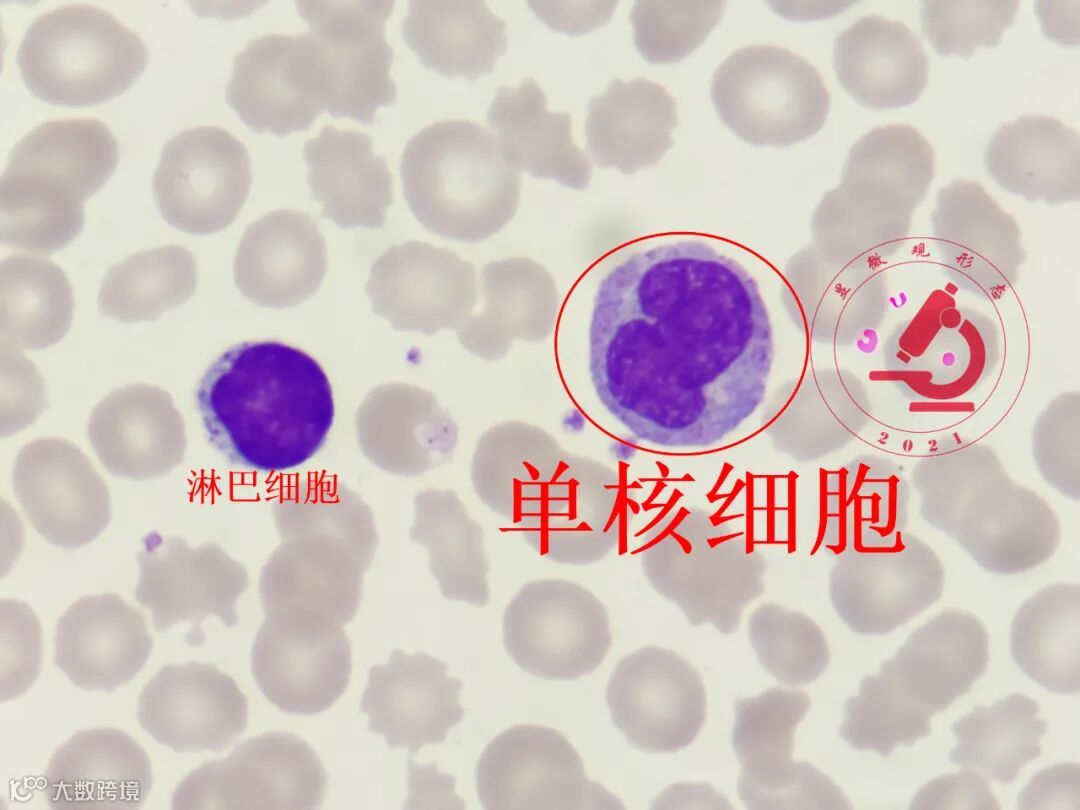
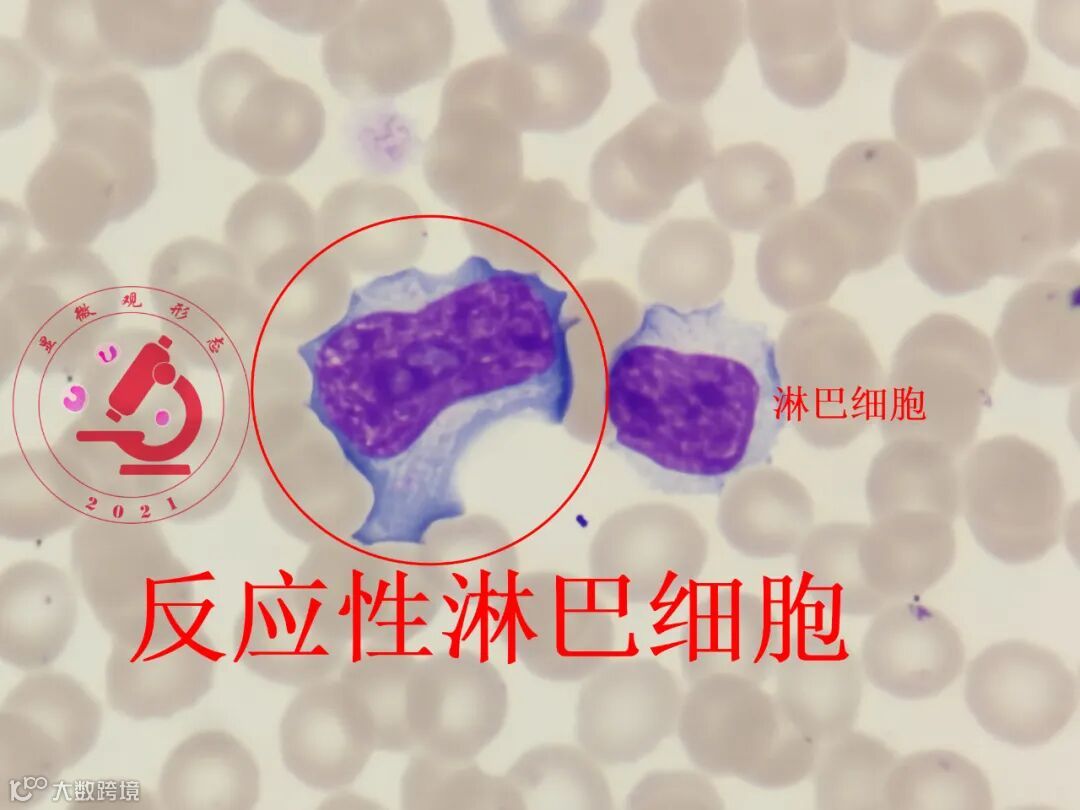
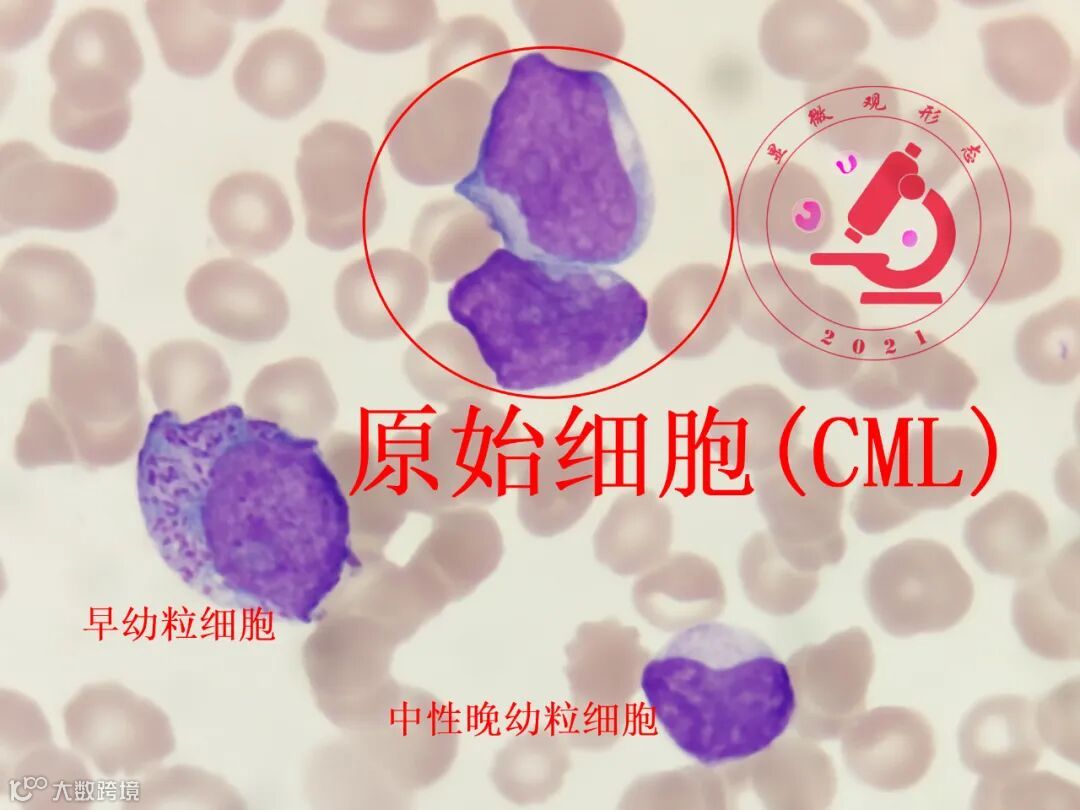
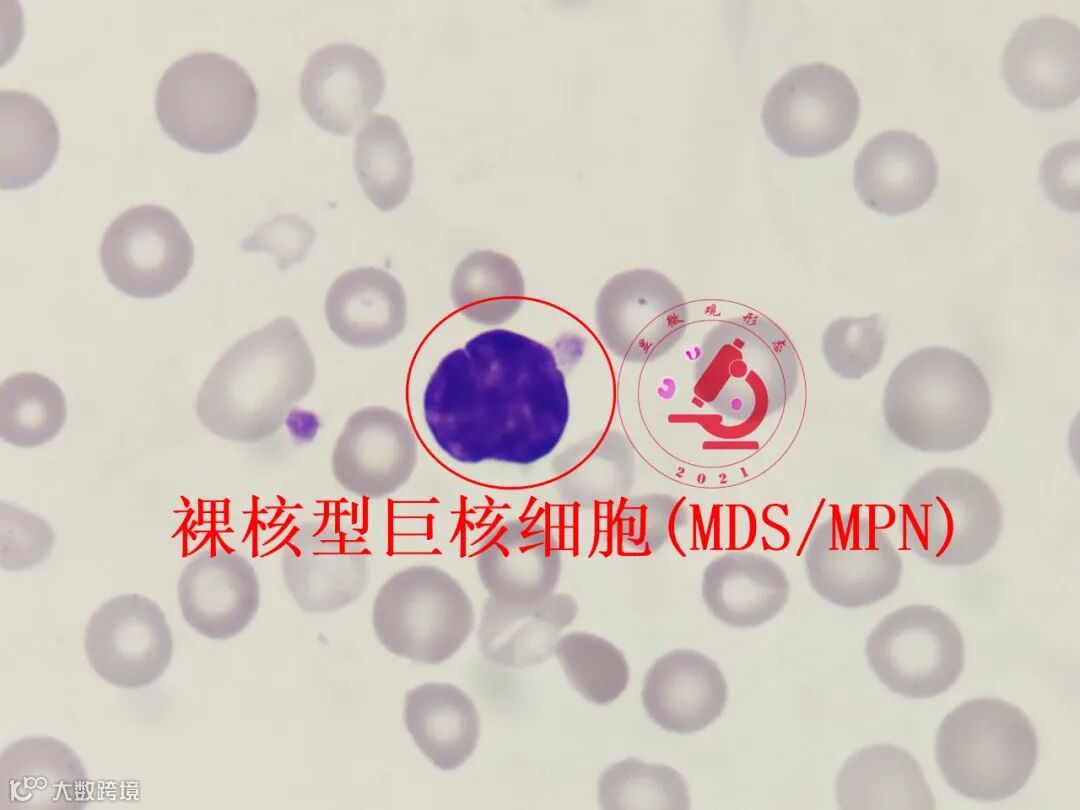
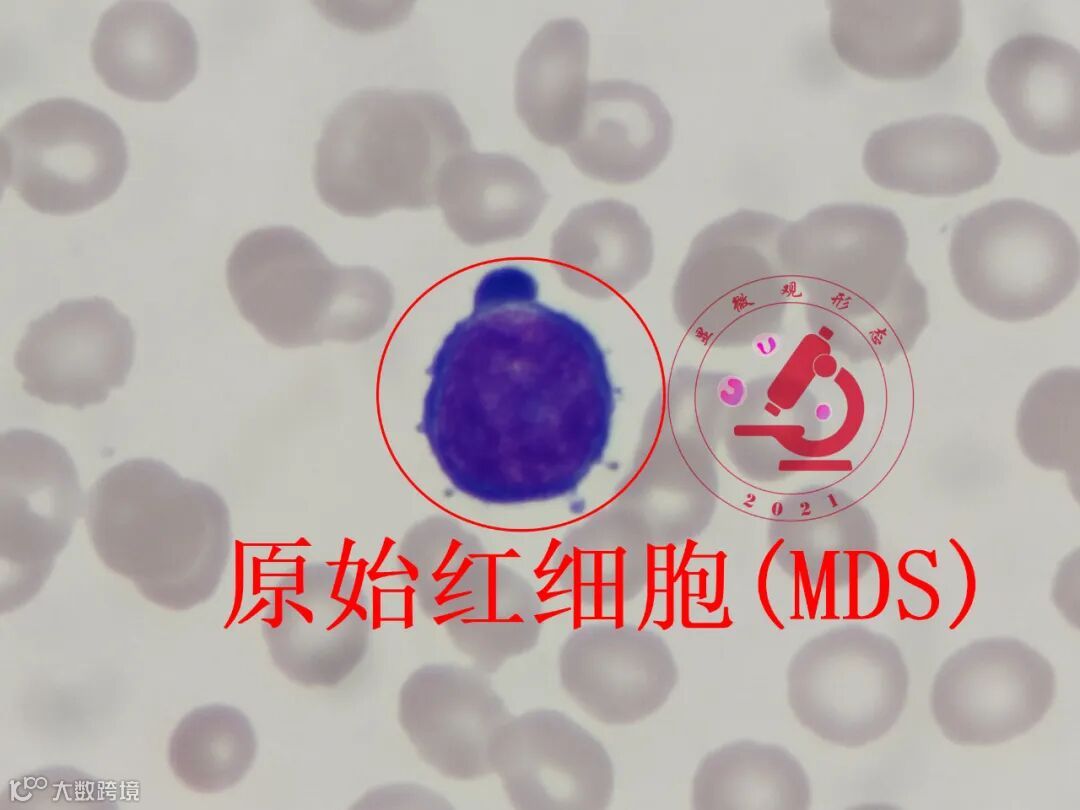
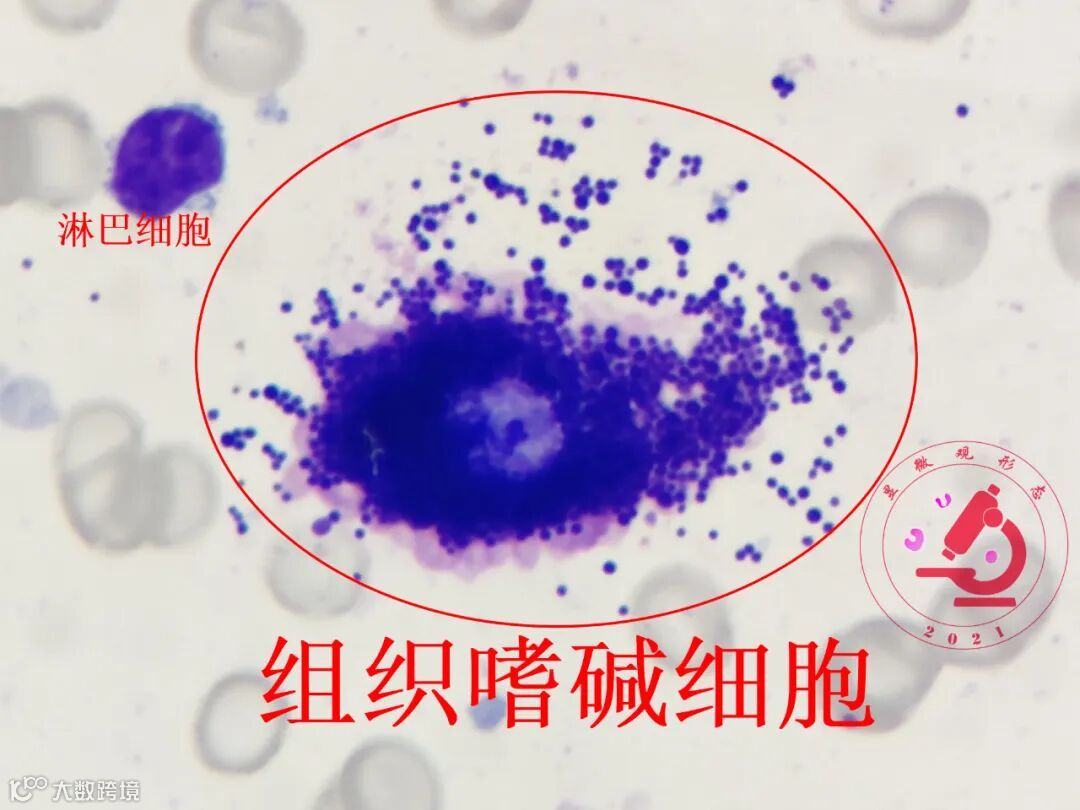

(点击空白处查看内容)
▼
(点击空白处查看内容)
▼
(点击空白处查看内容)
▼
(点击空白处查看内容)
▼

(点击空白处查看内容)
▼
(点击空白处查看内容)
▼

(点击空白处查看内容)
▼

(点击空白处查看内容)
▼

(点击空白处查看内容)
▼
单核细胞:胞体直径12~20μm,圆形或不规则,可见伪足;胞核不规则,呈扭曲、折叠状,或呈大肠状、马蹄形、S形、分叶形、笔架形等;核染色质疏松,可呈条索状、小块状,核仁消失;胞质多,呈浅灰蓝色或略带红色,半透明如毛玻璃状,胞质内可见细小、分布均匀的灰尘样紫红色颗粒,常有空泡。
临床血液学检验 ,第5版,人民卫生出版社,P46。
反应性淋巴细胞:也称异型淋巴细胞,胞体变大,10-30μm,胞体形态多样,有时受周围细胞挤压呈压陷状,胞质变多、胞质深蓝色,有的含有空泡、颗粒,胞核也较大,核规则或不规则,染色质变得疏松,有的甚至隐约可见核仁。Downey将异型淋巴细胞分为三型:Ⅰ型(空泡型、浆细胞型)、Ⅱ型(不规则型、单核细胞型)、Ⅲ型(幼稚型、幼稚淋巴细胞型)。
外周血细胞形态学检查技术,人民卫生出版社,P37。
原始细胞:原始粒细胞,胞体直径10~20μm,圆形或类圆形;胞核较大,圆形或类圆形,居中或略偏位;核染色质细颗粒状,排列均匀,平坦如一层薄沙,无浓集;核仁2-5个,较小,清楚,呈淡蓝色。胞质较少,呈蓝色或深蓝色,绕于核周,有时在近核某处浆色较淡,颗粒无或有少许细小颗粒。
临床血液学检验 ,第5版,人民卫生出版社,P41。
裸核型巨核细胞:其胞膜不完整,胞质无或有少许(胞质中有较细小、大小一致的淡紫红色颗粒),胞核巨大(直径约20-40μm),核型不规则,核染色质呈条状或块状。由于胞体较大,该细胞常位于血涂片的尾部,应注意与破碎细胞鉴别。
外周血细胞形态学检查技术,人民卫生出版社,P46。
原始红细胞:其胞体直径15~25μm,圆形或椭圆形,常有瘤状突起。胞核圆形,居中,核染色质呈颗粒状(较粗),核仁1~3个,大小不一,染浅蓝色,边界不清楚。胞质较多,深蓝色且不透明,有油画蓝感,在核周围常形成淡染区;胞质中无颗粒,但因核糖核酸丰富而自行聚集,使胞质中出现蓝色“颗粒”。
临床血液学检验 ,第5版,人民卫生出版社,P45。
组织嗜碱细胞:又称为肥大细胞。其胞体直径12~20μm,蝌蚪形、梭形、圆形、椭圆形、多角形等。胞核较小、圆形,常被颗粒遮盖,核染色质块状,无核仁。胞质较丰富,充满粗大、圆形、排列紧密、大小一致、深紫红色的颗粒,胞质的边缘常可见突出的颗粒,有时胞体周围可见淡紫红色的红晕。有的组织嗜碱细胞胞质中颗粒排列非常致密,整个细胞呈黑色,易误认为异物而被忽略。
临床血液学检验 ,第5版,人民卫生出版社,P51。

线索细胞:鳞状上皮细胞黏附大量加特纳菌或厌氧菌形成,细胞边缘锯齿状,核模糊不清,细胞上覆盖大量杆菌,表面毛糙。
体液细胞学图谱,湖南科学技术出版社,P143。

肿瘤细胞:黑色素瘤,细胞大小不一,呈单个散在分布或三两个聚集,少见成片脱落,核大且畸形,核仁大而明显,胞质较丰富、强嗜碱性,可见空泡,胞质内可发现大量的黑色素颗粒,有时可覆盖于核上,胞膜伪足样或瘤状突起明显。当合并出血时,背景可见大量的红细胞,同时可见红细胞吞噬细胞和含铁血黄素吞噬细胞。
脑脊液细胞学图谱及临床诊断思路,人民卫生出版社,P145。

肿瘤细胞:肿瘤细胞的异质性和多样化是腺癌细胞的重要特征,腺癌细胞具有八大特点,巨大核、云雾状胞浆、腺腔样排列、大分泌泡、低分化、多核和畸形核、单核细胞样变、粘连现象和糖原染色(PAS)强阳性等。
浆膜腔积液细胞图谱新解及病例分析,人民卫生出版社,P81。







